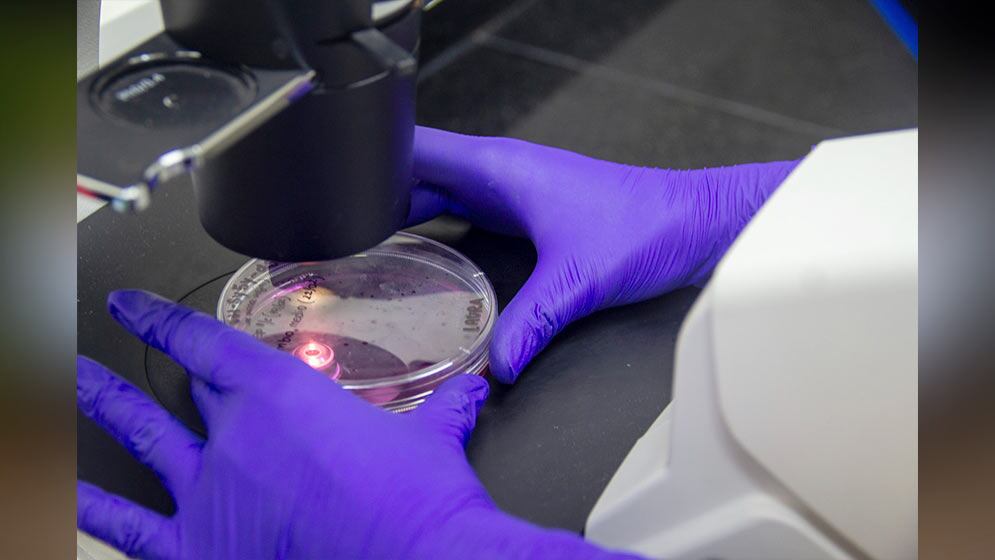
Los resultados del estudio provienen de modelos experimentales y aún necesitan confirmación en personas y en otras enfermedades./ Conicet

Un equipo de científicos de cinco países descubrió cómo las células defensoras del cuerpo logran ingresar a la piel inflamada en la psoriasis, al desprenderse de una capa de azúcares única que las recubre.
Según los autores, este avance, que fue publicado en la revista Science Signaling explica un mecanismo central de la inflamación cutánea y abre posibilidades para tratamientos con mayor precisión.
El estudio confirmó que los glóbulos blancos, encargados de las defensas, eliminan su propio “escudo” azucarado, llamado glicocálix de heparán sulfato, para atravesar los vasos sanguíneos y llegar al tejido afectado.

Durante mucho tiempo se creyó que solo los vasos realizaban cambios en su cubierta, pero el nuevo estudio mostró un rol clave e inesperado de los glóbulos blancos en el proceso inflamatorio.
El estudio estuvo liderado por Amy Saunders de la Universidad de Lancaster en el Reino Unido. Participaron científicos de instituciones de Reino Unido, Estados Unidos, Nueva Zelanda, Bélgica y Dinamarca.
También colaboraron la Universidad de Manchester, el Instituto Tecnológico de Massachusetts, la Universidad Victoria de Wellington, el VIB Center for Cancer Biology y la Universidad de Copenhague.
Psoriasis, un desafío inflamatorio

La psoriasis es una enfermedad inflamatoria que provoca que la piel se cubra con placas rojas y escamosas. Esas placas surgen porque el sistema inmune responde de manera equivocada y ataca el propio cuerpo.
Hasta este hallazgo, se pensaba que el paso de los glóbulos blancos a la piel dependía casi exclusivamente de los cambios en la superficie interna de los vasos sanguíneos, donde existe una especie de malla que protege las paredes vasculares.

Frente a preguntas no resueltas, los investigadores buscaron entender si las propias células inmunitarias, más allá de los vasos, tienen una cubierta parecida y cómo cambia ante la inflamación.
El objetivo fue comprobar si el glicocálix de los glóbulos blancos facilita su paso hacia la piel durante las crisis de psoriasis.
Esto permitiría entender mejor por qué el sistema inmune llega a las zonas dañadas y cómo se podrían evitar los brotes.
Cómo investigaron y qué vieron

El equipo utilizó modelos de laboratorio que imitaban la psoriasis en animales. Analizaron las células inmunitarias conocidas como leucocitos, que son las principales responsables de combatir infecciones y participar en la inflamación.
Descubrieron que esos leucocitos poseen una capa formada por glicanos, cadenas de azúcares complejas donde el heparán sulfato ocupa un lugar destacado.
Ante la inflamación, estas células liberan una enzima que elimina ese recubrimiento externo.
Cuando los glóbulos blancos pierden esta protección, pueden atravesar la pared de los vasos sanguíneos y penetrar en la piel dañada por la psoriasis. Si el desprendimiento de la cubierta no ocurre, su avance hacia el área afectada disminuye.

“Es realmente emocionante descubrir la importancia de esta barrera azucarada sobre las células inmunitarias”, expresó la doctora Saunders. Añadió que espera que este hallazgo ayude al desarrollo de futuros tratamientos.
El estudio comprobó que, tras perder la cobertura superficial, los glóbulos blancos llegan a la piel mucho más fácilmente y potencian la inflamación.
Para Douglas Dyer, otro de los líderes del estudio, “colaborar en este proyecto permitió redefinir cómo se entiende el movimiento de las células inmunitarias y buscar nuevas herramientas terapéuticas”.
El grupo de investigación advirtió que este fenómeno puede presentarse en otras enfermedades inflamatorias donde los glóbulos blancos también migran hacia los tejidos.
“Fue un proyecto realmente interesante durante mi doctorado, y espero que ayude a impulsar el interés en el papel de los azúcares del sistema inmunitario”, dijo Megan Priestley, que fue la primera autora del trabajo.
Los resultados ofrecen pruebas visuales y bioquímicas: cuando se administran fármacos que evitan la pérdida de esa estructura superficial, se reduce el ingreso de leucocitos a la piel afectada en los modelos estudiados.
Recomendaciones y proyecciones
El grupo investigador propuso explorar terapias futuras que bloqueen solo el desprendimiento de la barrera azucarada cuando la inflamación resulte perjudicial, sin debilitar la capacidad de defensa ante infecciones reales.
Reconocieron que los resultados se basan en modelos experimentales y que aún falta verificar si ocurre igual en personas y en otras enfermedades autoinmunes.
Aconsejaron diseñar estudios clínicos sobre medicamentos enfocados en la enzima que descompone este recubrimiento en los glóbulos blancos.

Los científicos estimaron que el hallazgo publicado podría ser útil en el estudio y control de trastornos como esclerosis múltiple, inflamación intestinal, diabetes y otras enfermedades donde la migración de células inmunitarias daña tejidos.
La investigación sugiere que intervenir ese mecanismo ofrecería nuevas estrategias para tratar diversos trastornos inflamatorios y autoinmunes.
